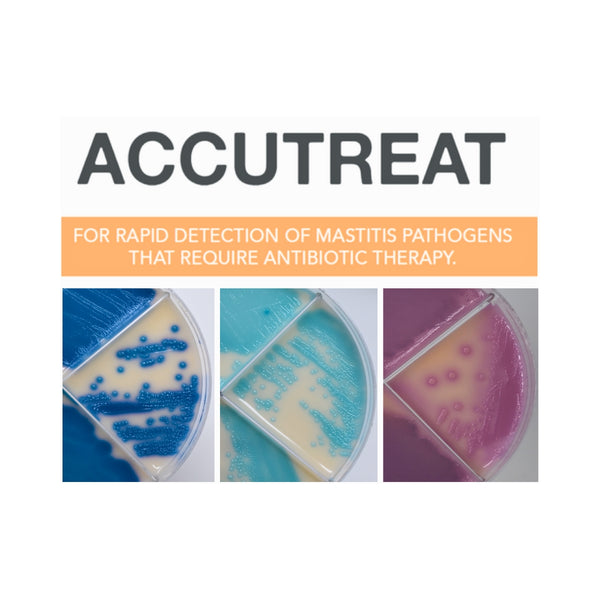

AccuTreat was created to allow dairy farmers to test clinical and sub-clinical of mastitis to identify and differentiate Gram-positive pathogens that may require antibiotic therapy. AccuTreat is accurate, practical, and affordable. Each package of AccuTreat contains 4 quadplates and each quadplate can test 4 different samples. Get on board with pathogen based therapy using the most cost effective tool on the market.
Additional Information
Selective Dry Cow Therapy
AccuTreat enables dairy farmers to reduce antibiotic usage and effectively test and identify dry cows infected with Gram-positive pathogens.
Blanket dry cow therapy is a strategy used to control udder health during the dry period in more than 90% of U.S. dairy operations. In herds with elevated somatic cell counts and a high prevalence of infection, dry cow therapy may lower significantly the rate of new dry period intra-mammary infection.
However, dairy farms that have high milk quality and lower incidence of mastitis may choose to perform selective dry cow therapy.
With AccuTreat, farmers can identify and treat only cows/quarters that currently have or are at risk for infections.